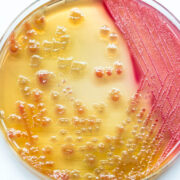
AdobeStock 117491077

Development of gender-specific thresholds in urine flow cytometry testing for urinary tract infection
Background A urinary tract infection (UTI) is an infection – usually bacterial – of any part of the urinary tract. Most commonly, a UTI would involve the lower urinary tract (urethra and bladder), and non-complicated lower UTIs are more common in women. Mild UTIs can resolve naturally, and pain killers, application of heat to the […]